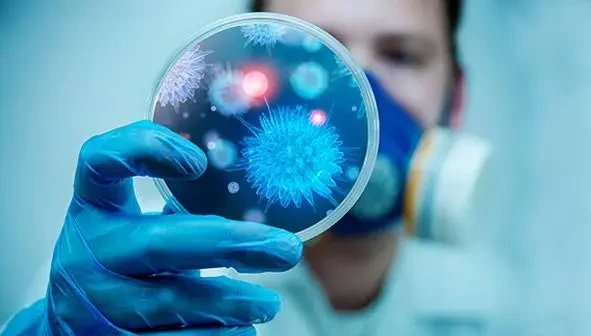
Kronik Hastalıklar ve Hasta Yakınları Kongresi Van’da düzenlenecek

2026-01-16 01:16:50 | Son Güncelleme : 2026-02-28 01:10:41
Van Valiliği ve Van Büyükşehir Belediyesi öncülüğünde, İSKON (İnsan Sağlığı Kongresi) iş birliğiyle “Kronik Hastalıklar ve Hasta Yakınları Kongresi” Van’da düzenlenecek.
“Birlikte Daha Güçlüyüz” temasıyla gerçekleştirilecek olan kongre, 2 Şubat 2026 Pazartesi günü Van Uygulama Oteli’nde yapılacak.
Kronik hastalıklarla yaşayan bireyler ve hasta yakınlarının karşılaştıkları zorluklara dikkat çekmek, farkındalık oluşturmak ve bilimsel bilgi paylaşımını artırmak amacıyla düzenlenecek kongrede alanında uzman akademisyenler ve hekimler katılımcılarla buluşacak.
Kongre, açılış konuşmasının ardından üç oturum ve söyleşilerle devam edecek. Program kapsamında; Kronik hastalıkların evlilik ve aile yaşamına etkileri, otizmde çocuğun iç dünyası ve aile yolculuğu, çocukluk çağı kronik hastalıklarında pediatristin rolü, kronik hastalıklarla yaşam, kanserin erken tanısı, bağırsak hastalıkları, sağlık okuryazarlığı ve hasta bilinci gibi başlıklarda sunumlar yapılacak.
Kongrede; Prof. Dr. Veysi Çeri, Prof. Dr. Kamuran Kahraman, Prof. Dr. Hilmi Ataseven, Prof. Dr. Hacı Mehmet Türk, Prof. Dr. Ahmet Altun, Doç. Dr. Yusuf Kayar, Doç. Dr. Dural Polat ve Uzman Psikolog Fazilet Seyidoğlu’nun da aralarında bulunduğu çok sayıda uzman isim bilgi ve deneyimlerini paylaşacak.
Gün boyu sürecek etkinlik, değerlendirme ve kapanış konuşmasıyla sona erecek.
Van Büyükşehir Belediyesinden yapılan açıklamada, kongre ile kronik hastalıklar konusunda toplumsal farkındalığın artırmasının yanı sıra hasta ve hasta yakınlarının yalnız olmadığının hissettirmesinin amaçlandığını belirtildi.
Bu habere ilk yorum yapan sen ol.